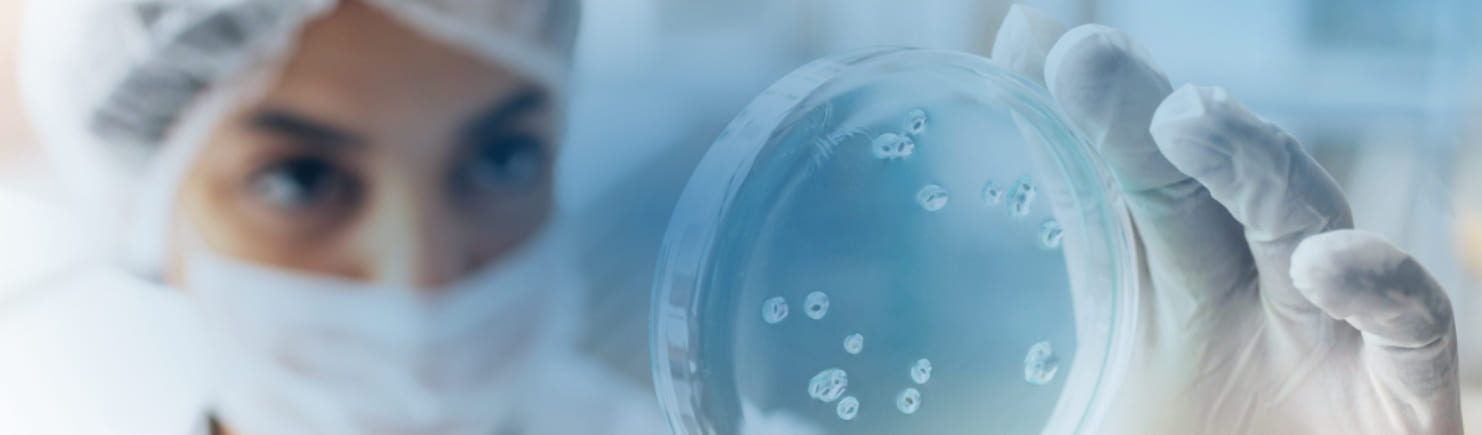

Consultoria Científica com objetivo de disseminar ciência

Scientia nasceu do sonho cultivado há mais de 10 anos por seus fundadores, Diego e Vinicius, e hoje está presente nas cidades de São Paulo e Cotia. Ao longo dessa trajetória, a experiência profissional e pessoal permitiu identificar de forma clara as necessidades e dificuldades enfrentadas por clientes em busca de uma consultoria técnico-científica especializada.
Assim, em meados de 2021, foi fundada a Scientia Consultoria Científica, uma empresa voltada para o desenvolvimento de soluções inovadoras em diversos setores, como farmacêutico, veterinário, farmoquímico, alimentício, cosmético, entre outros. O nome “Scientia”, de origem latina, significa ciência e conhecimento, refletindo a paixão de seus fundadores por esses valores.
Com sólida base acadêmica e pensamento inovador, adotamos como lema “Vamos fazer Scientia juntos”. Em 2022, ampliamos nosso portfólio de serviços com a inauguração do Scientia Lab, um laboratório de Pesquisa, Desenvolvimento e Inovação dedicado à descoberta de novos produtos para múltiplos segmentos.
No final de 2023, avançamos ainda mais com a aquisição da nossa segunda unidade, a Scientia Analítica — um laboratório com infraestrutura de excelência, equipamentos de última geração e equipe altamente qualificada. Esta unidade conta com certificação Reblas, garantindo a máxima qualidade nos serviços prestados.
Hoje, a Scientia está consolidada no mercado de prestação de serviços e vai muito além de seus fundadores. Tornou-se um time comprometido, formado por profissionais que são a verdadeira identidade da empresa, levando qualidade, dedicação e inovação a cada projeto.
Comprometemo-nos a oferecer serviços de alta qualidade, baseados na excelência operacional, na expertise da nossa equipe e no compromisso com a satisfação do cliente. Buscamos constantemente aprimorar nossos serviços, adaptando-nos às necessidades em evolução do mercado, enquanto mantemos um foco inabalável na ética, integridade e responsabilidade social.
Estamos dedicados a criar valor para nossos clientes, colaboradores e comunidade, contribuindo assim para o crescimento sustentável e o sucesso mútuo.
Buscamos continuamente novas oportunidades de crescimento, mantendo-nos ágeis e adaptáveis às mudanças do mercado, enquanto cultivamos uma cultura de colaboração, aprendizado e melhoria contínua. Nosso objetivo é sermos reconhecidos não apenas pelo que fazemos, mas pela forma como fazemos, promovendo impacto positivo em nossos clientes, funcionários e comunidades em que atuamos,
Integridade: Atuar com honestidade, transparência e ética em todas as situações, mantendo a confiança dos clientes e parceiros comerciais.
Respeito: Valorizar e respeitar a diversidade, opiniões e necessidades individuais de clientes, funcionários e comunidade em geral.
Comprometimento com o Cliente: Colocar o cliente no centro de todas as decisões e esforços, buscando entender suas necessidades e superar suas expectativas.
Inovação: Promover uma cultura de criatividade e inovação, buscando constantemente novas formas de agregar valor aos serviços oferecidos e melhorar a experiência do cliente.
Responsabilidade Social e Ambiental: Assumir responsabilidade pelo impacto social e ambiental das operações da empresa, buscando contribuir positivamente para a comunidade e o meio ambiente.
Trabalho em Equipe: Fomentar um ambiente de colaboração, respeito mútuo e trabalho em equipe, reconhecendo que o sucesso é alcançado através do esforço conjunto de todos os membros da organização.
Aprendizado Contínuo: Promover uma cultura de aprendizado e desenvolvimento pessoal e profissional, incentivando a busca por conhecimento e o aprimoramento constante das habilidades.
- Missão
-
Fazendo Scientia, nossa missão é fornecer soluções inovadoras e confiáveis, superando as expectativas dos nossos clientes em cada interação.
Comprometemo-nos a oferecer serviços de alta qualidade, baseados na excelência operacional, na expertise da nossa equipe e no compromisso com a satisfação do cliente. Buscamos constantemente aprimorar nossos serviços, adaptando-nos às necessidades em evolução do mercado, enquanto mantemos um foco inabalável na ética, integridade e responsabilidade social.
Estamos dedicados a criar valor para nossos clientes, colaboradores e comunidade, contribuindo assim para o crescimento sustentável e o sucesso mútuo.
- Visão
-
Nossa visão é ser reconhecido como o parceiro de escolha em soluções de serviços, líder em inovação, qualidade e confiabilidade. Estamos comprometidos em expandir nossa presença global, ampliando nossa gama de serviços e alcançando a excelência em cada interação com nossos clientes.
Buscamos continuamente novas oportunidades de crescimento, mantendo-nos ágeis e adaptáveis às mudanças do mercado, enquanto cultivamos uma cultura de colaboração, aprendizado e melhoria contínua. Nosso objetivo é sermos reconhecidos não apenas pelo que fazemos, mas pela forma como fazemos, promovendo impacto positivo em nossos clientes, funcionários e comunidades em que atuamos,
- Valores
-
Excelência: Compromisso com a qualidade e o profissionalismo em todas as interações com os clientes, buscando constantemente aprimorar os serviços prestados.
Integridade: Atuar com honestidade, transparência e ética em todas as situações, mantendo a confiança dos clientes e parceiros comerciais.
Respeito: Valorizar e respeitar a diversidade, opiniões e necessidades individuais de clientes, funcionários e comunidade em geral.
Comprometimento com o Cliente: Colocar o cliente no centro de todas as decisões e esforços, buscando entender suas necessidades e superar suas expectativas.
Inovação: Promover uma cultura de criatividade e inovação, buscando constantemente novas formas de agregar valor aos serviços oferecidos e melhorar a experiência do cliente.
Responsabilidade Social e Ambiental: Assumir responsabilidade pelo impacto social e ambiental das operações da empresa, buscando contribuir positivamente para a comunidade e o meio ambiente.
Trabalho em Equipe: Fomentar um ambiente de colaboração, respeito mútuo e trabalho em equipe, reconhecendo que o sucesso é alcançado através do esforço conjunto de todos os membros da organização.
Aprendizado Contínuo: Promover uma cultura de aprendizado e desenvolvimento pessoal e profissional, incentivando a busca por conhecimento e o aprimoramento constante das habilidades.

Diretor Científico e Fundador
Diego é natural de Londrina (PR) e, na infância, sonhava em ser jogador de futebol. Durante o ensino médio, conciliou os estudos em uma escola pública no período da manhã com um curso técnico à noite, demonstrando desde cedo comprometimento com sua formação.
Sua trajetória acadêmica começou a tomar forma com o ingresso no curso de Bacharelado em Química na Universidade Estadual de Londrina (UEL), onde recebeu o prêmio de melhor Trabalho de Conclusão de Curso na área de inovação, graças ao seu projeto sobre automação em sistemas hidropônicos.
Dando continuidade à formação, tornou-se Mestre em Química também pela UEL, enquanto atuava no setor de Desenvolvimento Analítico da Sandoz do Brasil. Em 2011, mudou-se para Ribeirão Preto para cursar o Doutorado na Faculdade de Filosofia, Ciências e Letras da USP, desenvolvendo metodologias analíticas por LC-MS voltadas à avaliação de biomarcadores em pacientes com esquizofrenia atendidos pela Faculdade de Medicina da USP.
Após concluir o doutorado, Diego passou a integrar a equipe do Aché Laboratórios Farmacêuticos em São Paulo, onde permaneceu por seis anos. Nos dois últimos anos, atuou como Pesquisador no Núcleo de Inovação, sendo responsável pela aquisição, implementação e gestão de novas tecnologias aplicadas ao Desenvolvimento Analítico.
Ao longo de sua jornada acadêmica e profissional, Diego acumulou ampla experiência em instrumentação analítica, métodos cromatográficos ortogonais, espectrometria de massas e técnicas de preparo de amostras, sempre integrando ferramentas estatísticas no processo de desenvolvimento analítico.
Toda essa trajetória multidisciplinar e vivência em diferentes ambientes científicos e corporativos foram fundamentais para a criação da Scientia Consultoria Científica, empresa que nasceu com o propósito de disseminar conhecimento e promover a ciência como ferramenta de transformação.

Diretor Científico e Fundador
Vinicius é natural de Ribeirão Preto (SP) e teve sua formação integral em escolas públicas, o que sempre encarou como um desafio motivador em sua trajetória.
Buscando novos horizontes, mudou-se para Londrina, onde concluiu a graduação e o mestrado em Química pela Universidade Estadual de Londrina (UEL). Mais tarde, retornou a Ribeirão Preto para cursar o doutorado na Faculdade de Filosofia, Ciências e Letras da Universidade de São Paulo.
Durante o doutorado, teve a oportunidade de realizar um período de Doutorado Sanduíche na Universidade de Waterloo, no Canadá, integrando o grupo de pesquisa do renomado Prof. Janusz Pawliszyn, inventor da técnica de microextração em fase sólida (SPME).
Após a conclusão do doutorado, seguiu para o Instituto de Química de São Carlos (USP) para realizar seu pós-doutorado. Com uma sólida carreira acadêmica construída ao longo de mais de uma década, Vinicius deu um novo passo ao assumir a posição de Especialista em Desenvolvimento Analítico no Aché Laboratórios Farmacêuticos, em São Paulo.
Vinicius possui vasta experiência em preparo de amostras e instrumentação analítica, com atuação nas áreas de espectrometria de massas (LC-MS/MS e GC-MS/MS), detectores CAD e ELSD, UHPLC, HPLC preparativo e cromatografia bidimensional (2D-HPLC). Também é especialista em quimiometria, aplicando os princípios de Quality by Design (QbD) desde 2009.
Como fruto de sua intensa dedicação à ciência, é autor de mais de 20 artigos publicados em periódicos nacionais e internacionais de prestígio, além de atuar como revisor científico para revistas como Journal of the Brazilian Chemical Society (JBCS) e Analytica Chimica Acta (ACA).